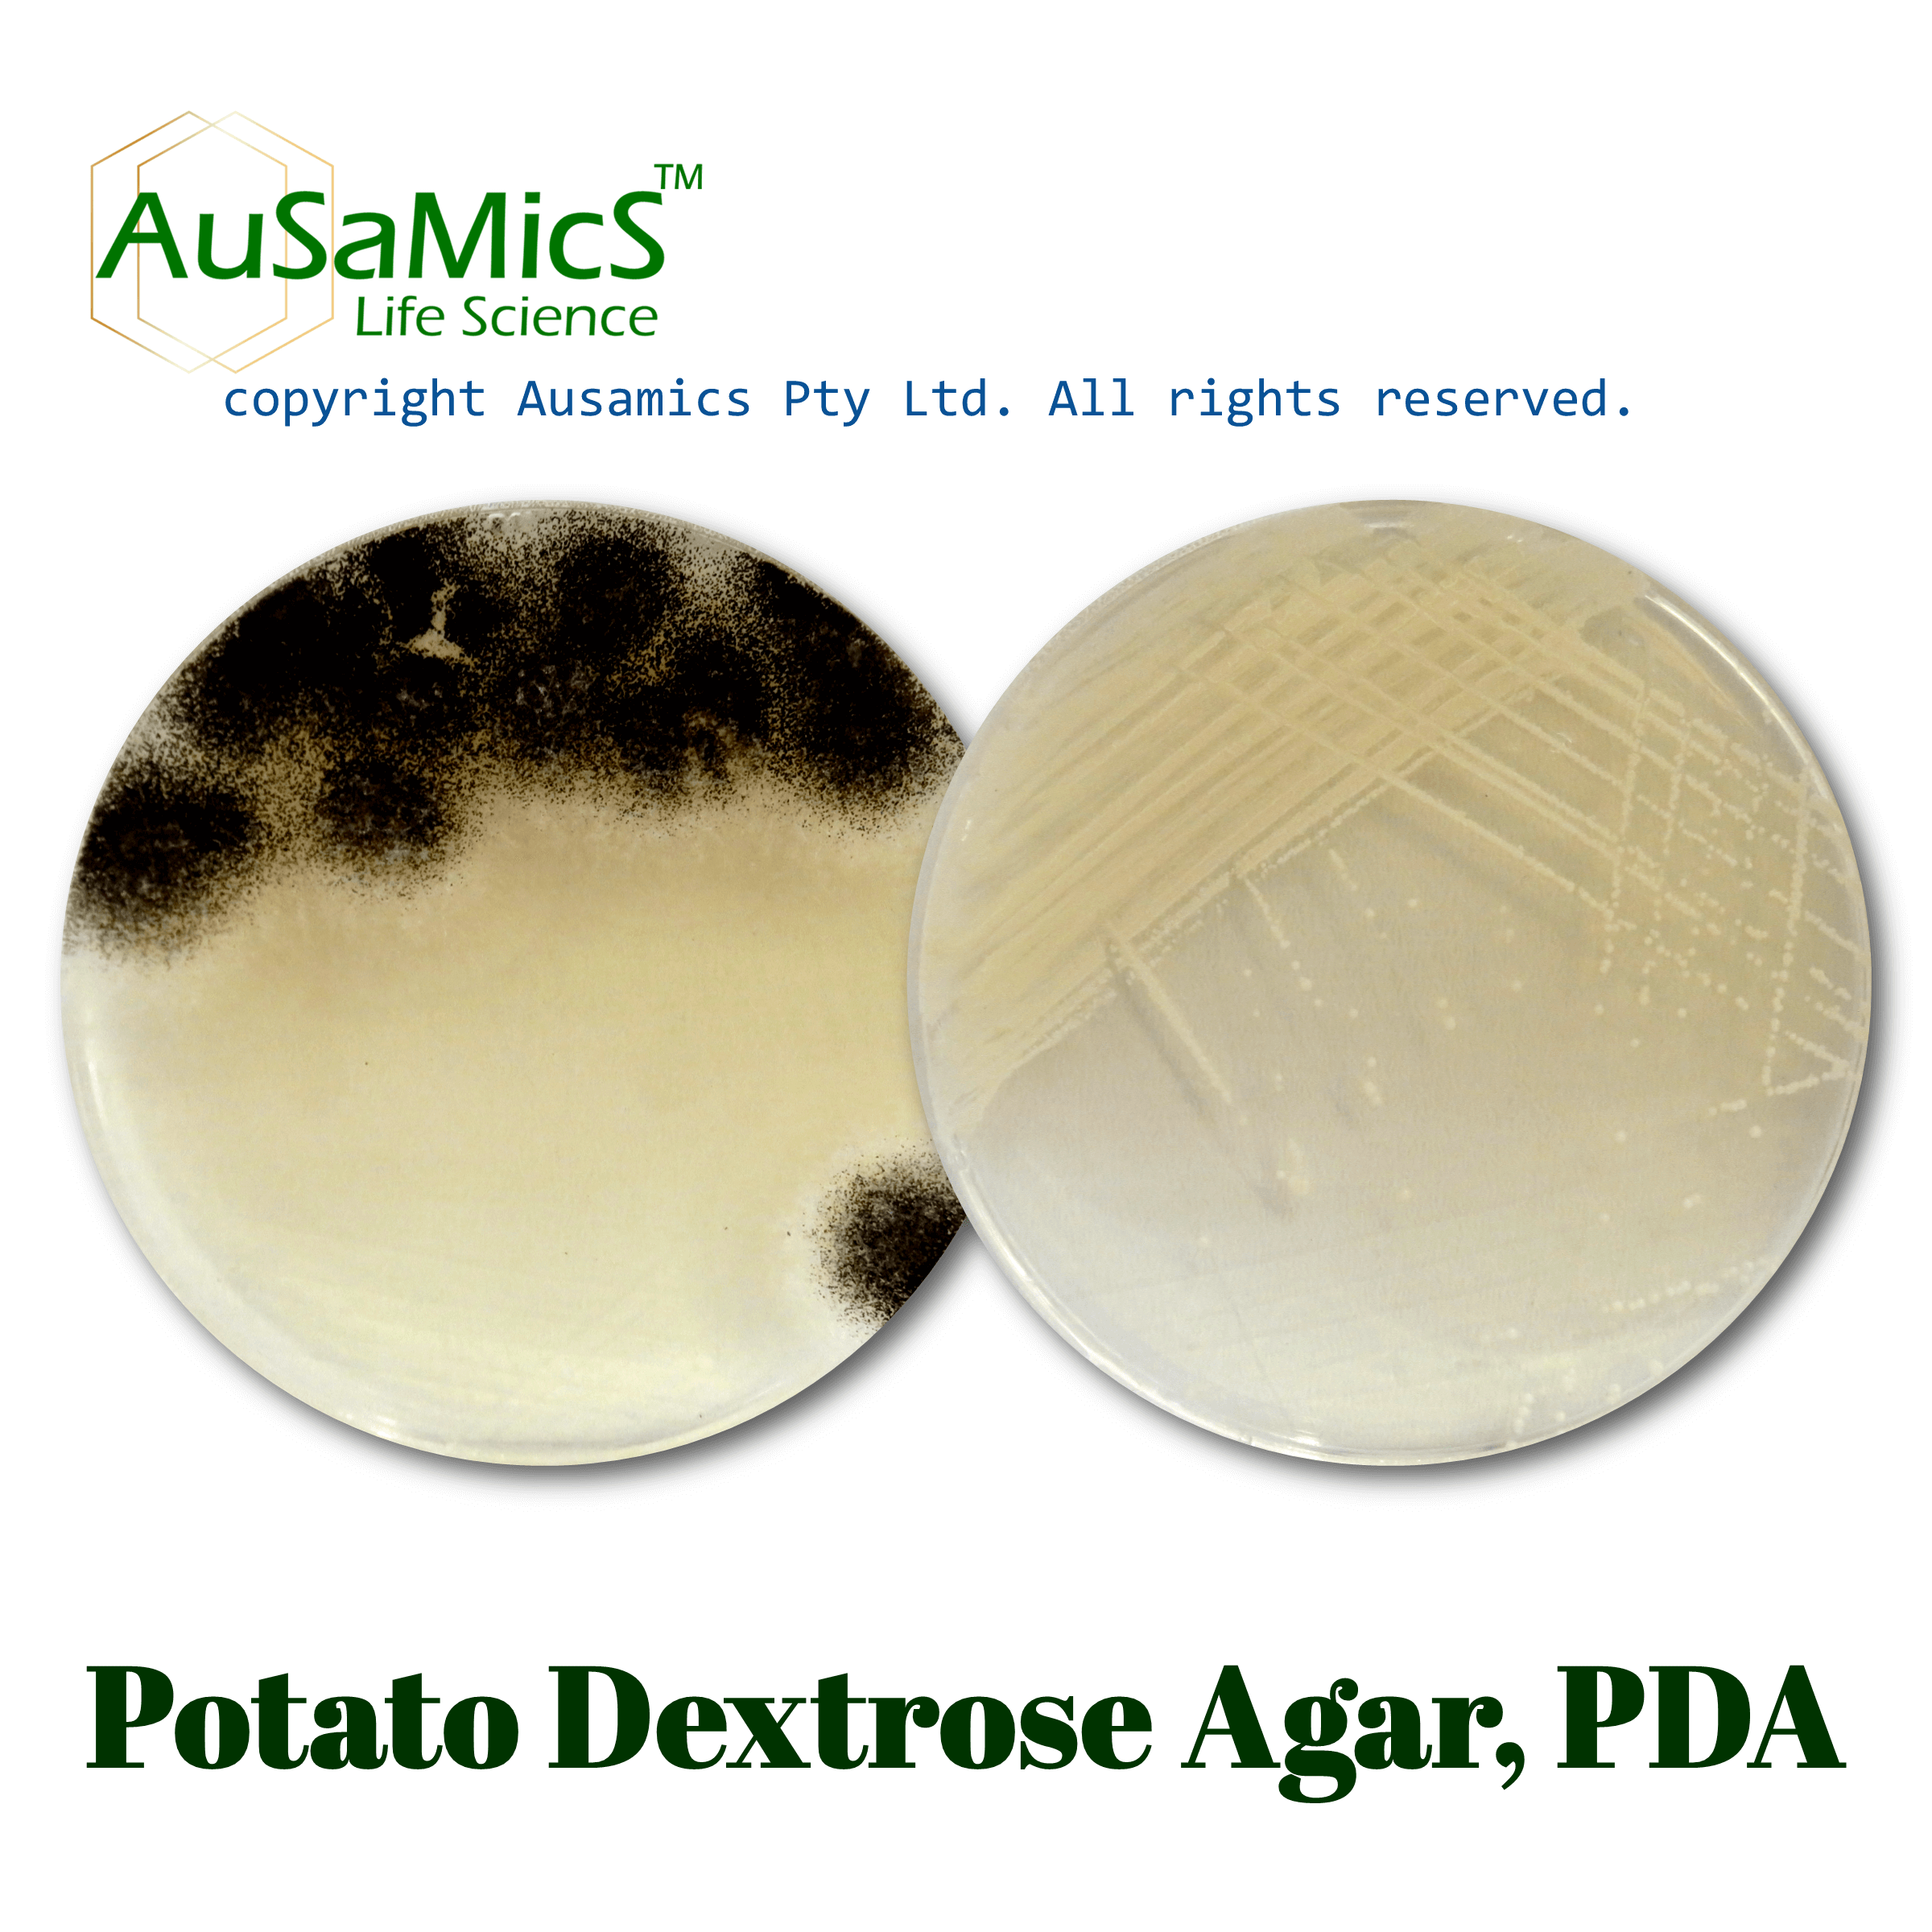
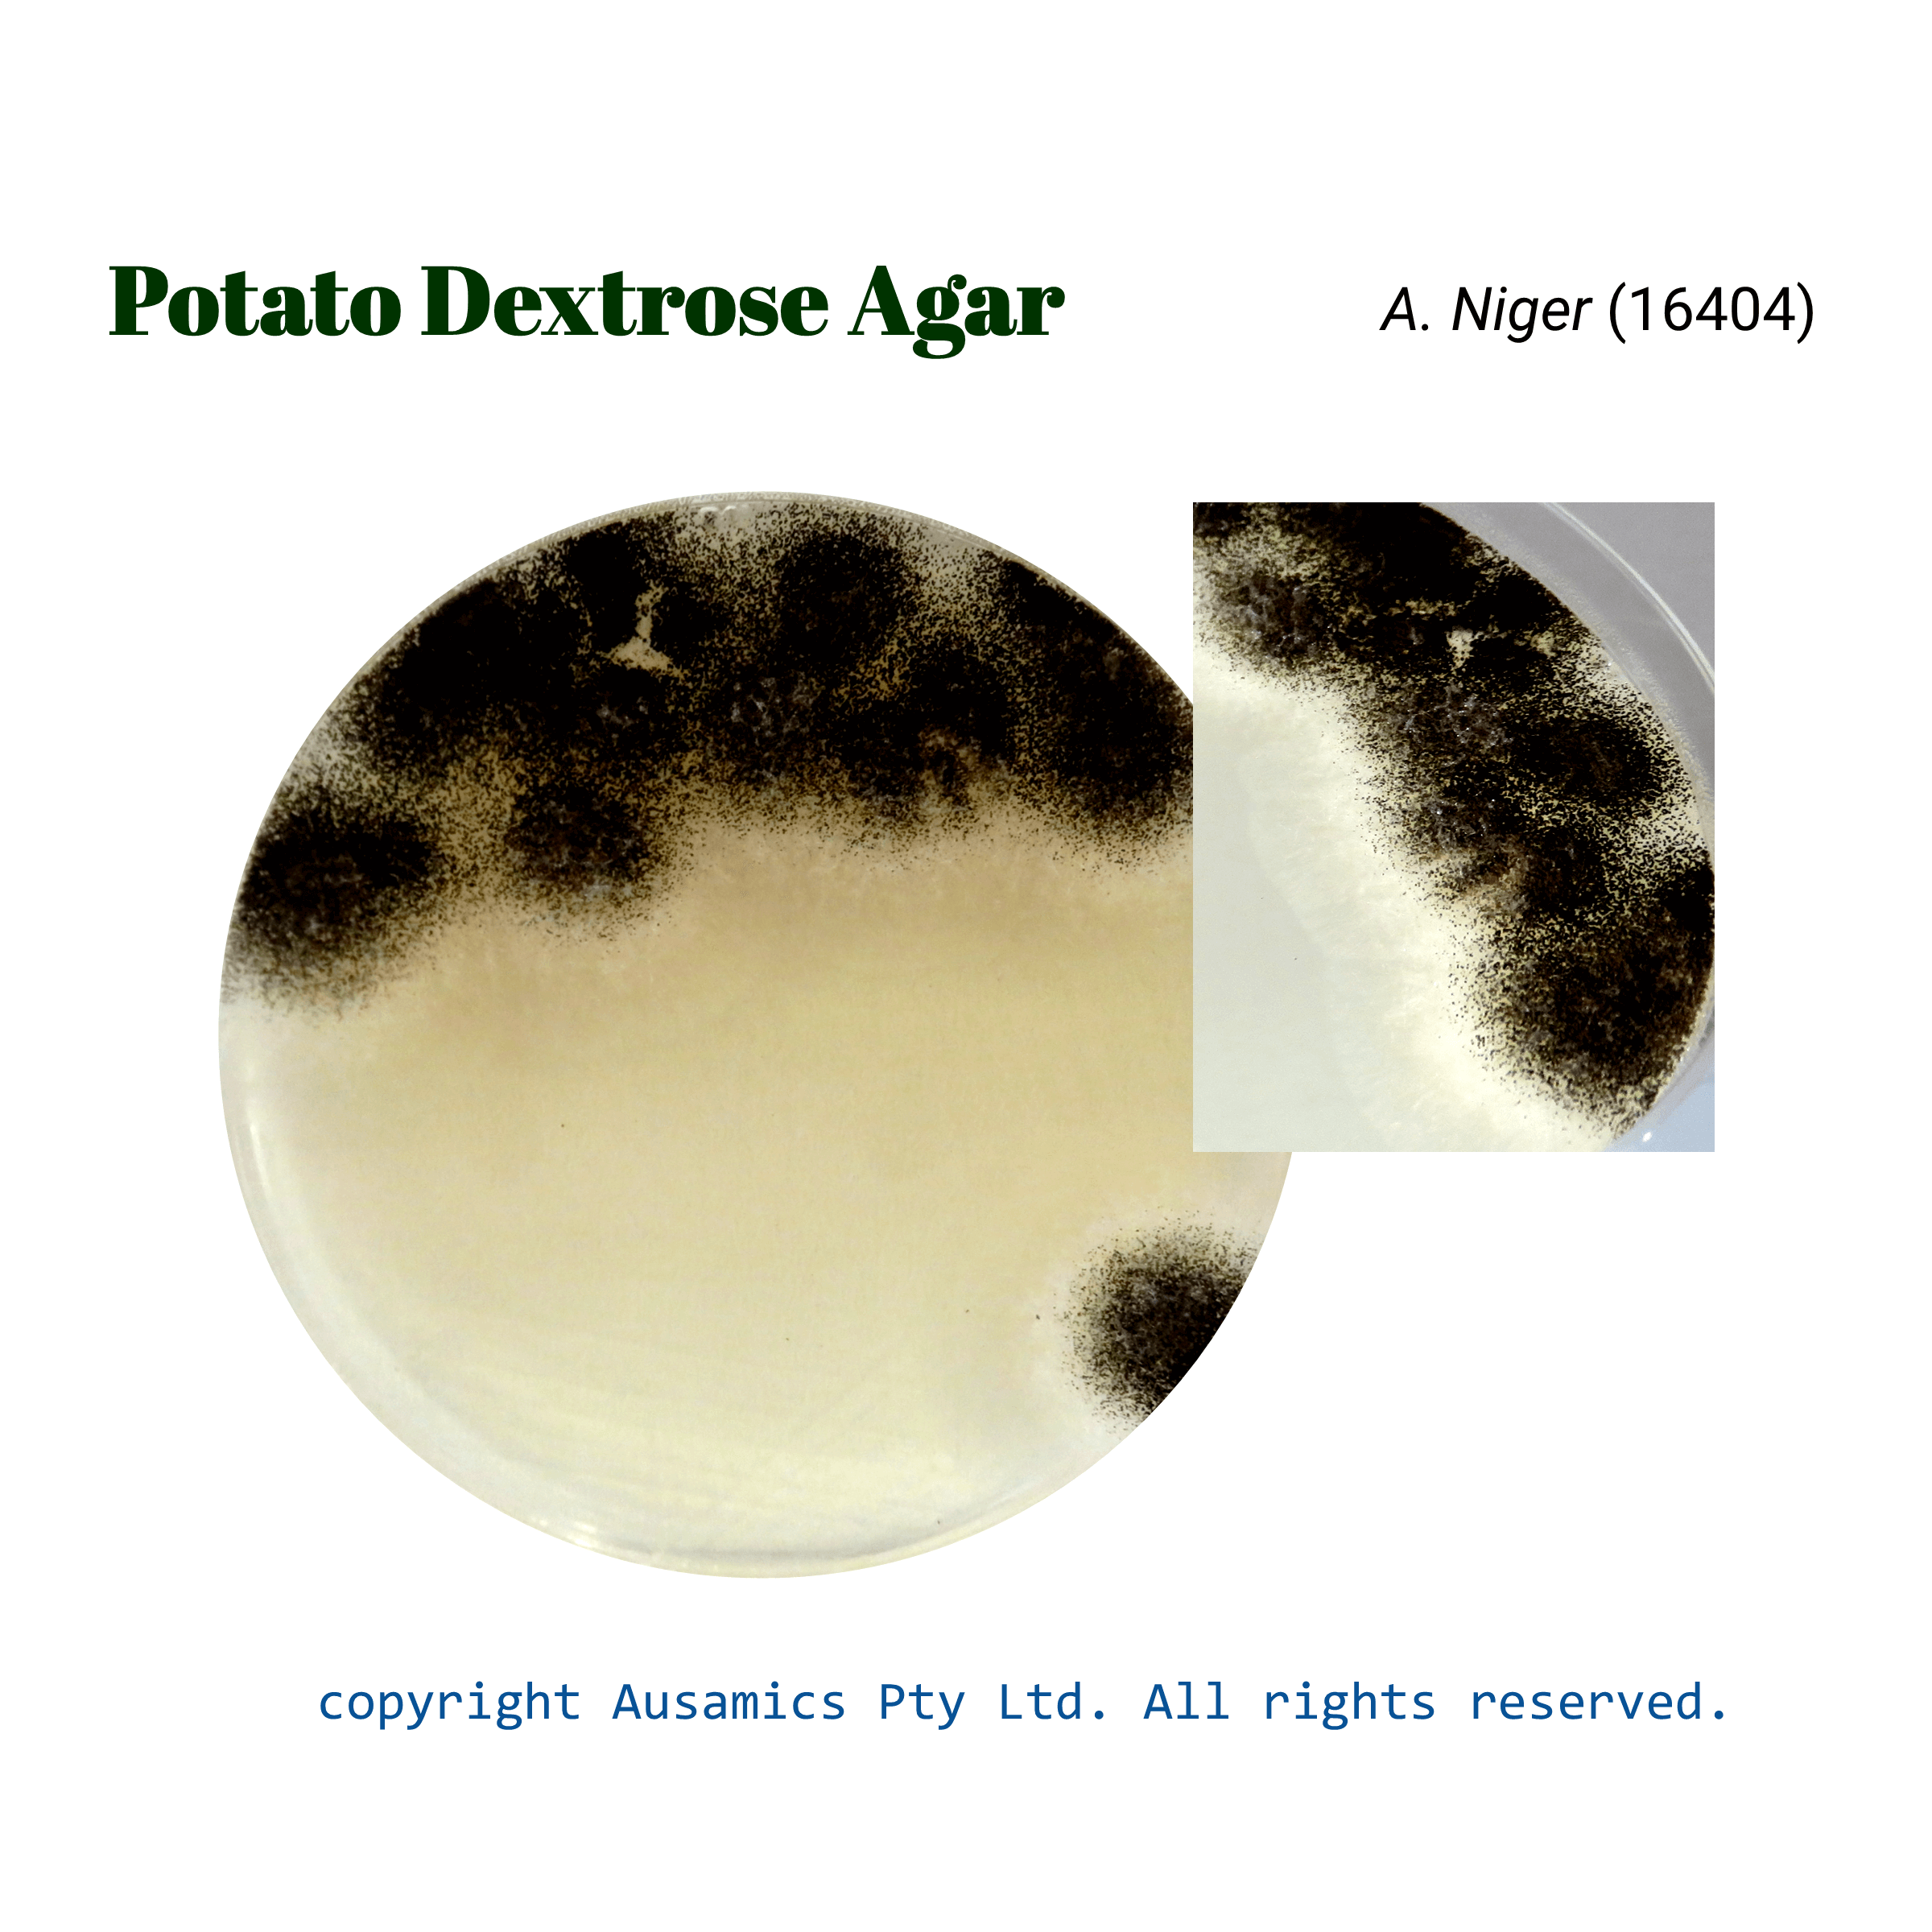
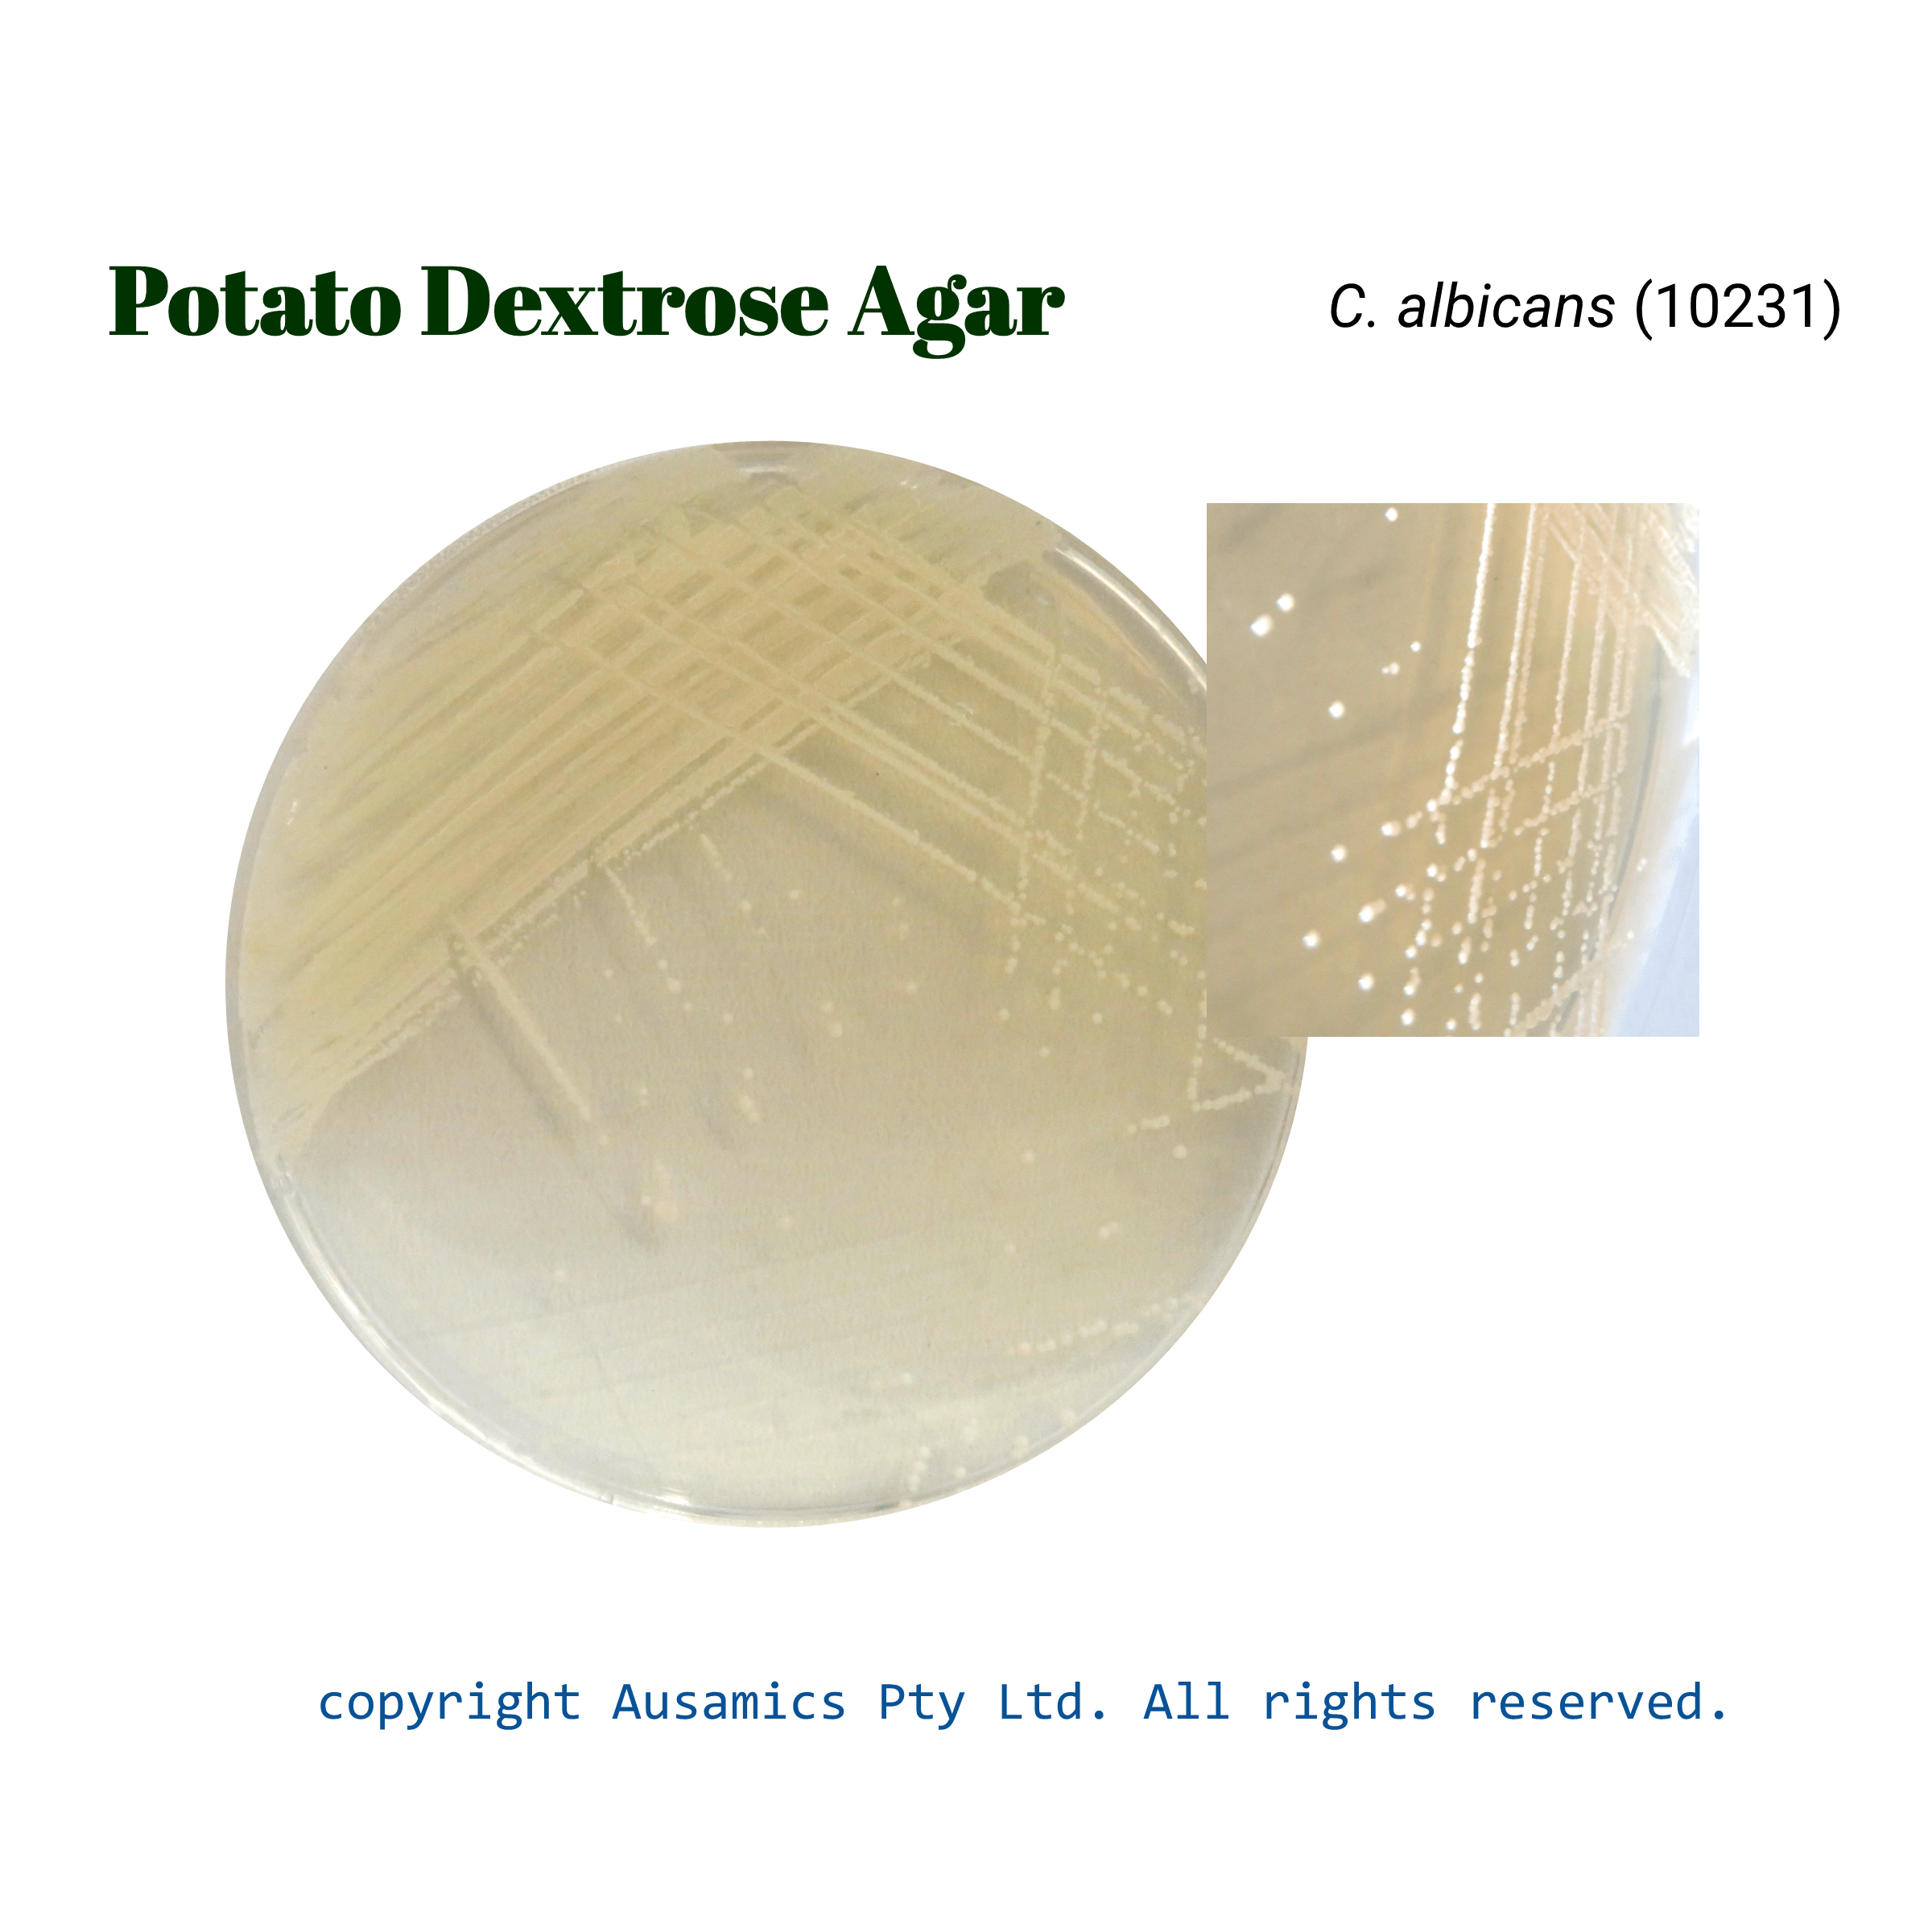

Potato Dextrose Agar, PDA
For the cultivation, isolation and enumeration of yeasts and molds from foodstuffs and other material
- Description
- Composition
- Quality Control
- Microbial Test Results
A versatile media that is well-known for encouraging the growth of molds and yeasts is Potato Dextrose Agar (PDA). It has a balance of carbohydrates and potato infusion that was first created in 1970 by Beever and Bollard. This particular composition promotes the growth of accompanying bacteria while at the same time fostering the growth of fungal microorganisms. The pH can be adjusted to approximately 3.5 to maximize its utility for fungal counts. The characteristic morphology of fungi grown on PDA facilitates identification.
PDA is used in the cultivation, isolation and enumeration of molds and yeasts in a variety of materials, especially food. The medium is suitable for food testing since it complies with the guidelines set forth by reputable organizations like the United States Pharmacopeia and the American Public Health Association. Potatoes and dextrose provide a nutrient-rich base that promotes strong fungal development. Agar is added to promote sporulation. To stop agar hydrolysis, it is essential not to heat the medium after acidification. It is possible to modify PDA by adding acids or antibiotics to stop the growth of bacteria.
Storage
Keep the container at 15-30 °C and prepared medium at 2-8 °C.
| Composition | (gr/L) |
| Agar | 15 |
| Dextrose | 20 |
| Final pH at 25°C | 5.6 ± 0.2 |
| Potato Infusion | 4 |
| Dehydrated Appearance | Light beige, free-flowing, homogeneous (may contain small dark particles). |
| Prepared Appearance | Light amber, slightly opalescent. |
| Reaction of 3.9% Solution at 25°C | pH 5.6 ± 0.2 |
| For 18 to 48 hours, incubate at 25-30°C. (up to 7 days for T. mentagrophytes). For Aspergillus brasiliensis, incubate at 20-25°C for 5 days. | |
| Organism (ATCC) | Recovery |
| Candida albicans (10231) | Good |
| Saccharomyces cerevisiae (9763) | Good |
| Trichophyton mentagrophytes (9533) | None to poor |
| Aspergillus brasiliensis (niger) (16404) | Good |